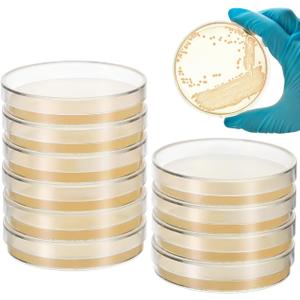
Baluue 10Pcs Nutrient Agar Petri Dishes Science Project Kit, 70mm Pre-Poured Agar Plates, Laboratory Experiment Prepoured Supplies for Students (7CX7cm)

Lead Test Kit 2Bottle Lead Testing Kit for Dishes & Paint, Instant Lead Test Swabs, Lead Tester with Free Lab Analyses Included
Condition: New Incomplete
Pickup Details
| Friday, Nov 14 | 09:00AM - 02:00PM (Appointment only) |
| Saturday, Nov 15 | 08:30AM - 02:00PM |
| Monday, Nov 17 | 11:00AM - 06:30PM (Appointment only) |
| Tuesday, Nov 18 | 12:00PM - 06:30PM |
Product Details
| SKU | OLARR5440279 |
| ASIN | B0FM41M9R7 |